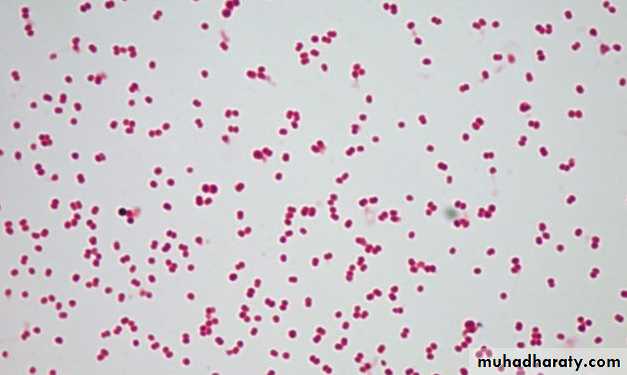
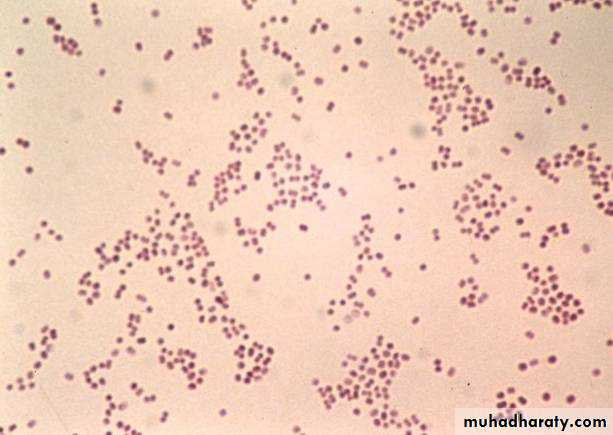
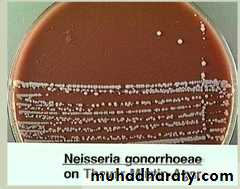

Neisseria
MSc. Sarah Ahmed• Many commensals
• Two important human pathogens:• Neisseria gonorrhoeae (gonococci)
• Neisseria meningitidis ( meningococci)
General Characters of the Genus
1. Gram-negative diplococci
CULTURE & CULTURAL CHARACTERISTICS:
fastidious organisms do not grow on ordinary culture media.
aerobic but may grow anaerobically alsoIt is essential to provide 5-10% CO2.
The optimum temperature for growth is 35-36°C & optimum pH is 7.2-7.6.
2- Oxidase positive (the key test of the genus)D. Identification:
1- Identification at the genus levelGram –ve diplococci Oxidase +ve
2)Culture-
Non- specific-Chocolate agar- Heat lysed sheep blood+ Agar
Specific culture media-
A) Modified New York City media (MNYCM)
Heat lysed sheep blood+ Agar+ Antibiotic (Lincomycin, Colistin, Nystatin, Trimethoprim)
B) Thayer Martin Media (TMM)
Heat lysed sheep blood+ Agar+ Antibiotic (Vancomycin, Colistin, Nystatin, Trimethoprim)
Neisseria meningitidis
Colonies growth on New_York_City_Medium Agar
Incubate at 37C for 18-24 hrs in microaerophilic environment by candle jar.
Observation- 0.5-1 mm, circular, convex, graiysh white translucent colony.) Biochemical test-
Oxidase test- Positive testcarbohydrate utilization test (CUT)-
N. Gonorrhoeae ferment glucose but not maltose.
N. meningitidis ferment both.
• Biochemical reactions:
Ferments only glucose• but not maltose.
•
Glucose
Maltose